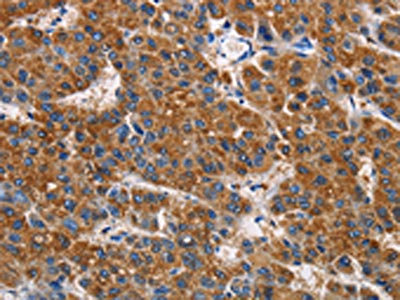

APLNR Antibody
-
中文名稱:APLNR兔多克隆抗體
-
貨號:CSB-PA229044
-
規格:¥1100
-
圖片:
-
The image on the left is immunohistochemistry of paraffin-embedded Human liver cancer tissue using CSB-PA229044(APLNR Antibody) at dilution 1/50, on the right is treated with fusion protein. (Original magnification: ×200)
-
The image on the left is immunohistochemistry of paraffin-embedded Human thyroid cancer tissue using CSB-PA229044(APLNR Antibody) at dilution 1/50, on the right is treated with fusion protein. (Original magnification: ×200)
-
-
其他:
產品詳情
-
Uniprot No.:
-
基因名:
-
別名:APLNR; AGTRL1; APJ; Apelin receptor; Angiotensin receptor-like 1; G-protein coupled receptor APJ; G-protein coupled receptor HG11
-
宿主:Rabbit
-
反應種屬:Human,Mouse,Rat
-
免疫原:Fusion protein of Human APLNR
-
免疫原種屬:Homo sapiens (Human)
-
標記方式:Non-conjugated
-
抗體亞型:IgG
-
純化方式:Antigen affinity purification
-
濃度:It differs from different batches. Please contact us to confirm it.
-
保存緩沖液:-20°C, pH7.4 PBS, 0.05% NaN3, 40% Glycerol
-
產品提供形式:Liquid
-
應用范圍:ELISA,IHC
-
推薦稀釋比:
Application Recommended Dilution ELISA 1:1000-1:5000 IHC 1:50-1:200 -
Protocols:
-
儲存條件:Upon receipt, store at -20°C or -80°C. Avoid repeated freeze.
-
貨期:Basically, we can dispatch the products out in 1-3 working days after receiving your orders. Delivery time maybe differs from different purchasing way or location, please kindly consult your local distributors for specific delivery time.
-
用途:For Research Use Only. Not for use in diagnostic or therapeutic procedures.
相關產品
靶點詳情
-
功能:Receptor for apelin receptor early endogenous ligand (APELA) and apelin (APLN) hormones coupled to G proteins that inhibit adenylate cyclase activity. Plays a key role in early development such as gastrulation, blood vessels formation and heart morphogenesis by acting as a receptor for APELA hormone. May promote angioblast migration toward the embryonic midline, i.e. the position of the future vessel formation, during vasculogenesis. Promotes sinus venosus (SV)-derived endothelial cells migration into the developing heart to promote coronary blood vessel development. Plays also a role in various processes in adults such as regulation of blood vessel formation, blood pressure, heart contractility and heart failure.; (Microbial infection) Alternative coreceptor with CD4 for HIV-1 infection; may be involved in the development of AIDS dementia.
-
基因功能參考文獻:
- these data... suggest that APLNR alteration neither by mutation nor expression loss is common in colorectal and prostate cancer PMID: 29573866
- leptin, leptin receptor and apelin receptor genes are associated with susceptibility to coronary artery disease and hypertension PMID: 29883719
- Studies indicate that the Elabela-APJ (apelin receptor) axis may protect against pressure overload-induced heart failure. PMID: 29036564
- The high APJ expression has significantly higher rates of tumor invasion, local lymph node, and distant metastasis (all p < 0.001). PMID: 28514205
- The mutation of polymorphism rs10501367 in APJ gene decreased risk of hypertension in Chinese males. PMID: 29800734
- these observations suggest apelin-APJ signaling in hepatocytes functions to protect against lipid accumulation in liver through two signaling pathways, that is, via AMPK activation and PPARalpha induction. PMID: 28821440
- 916 ischemic stroke patients were recruited for the study. For age at ischemic stroke onset, no significant association was identified with the variant rs9943582 of APLNR in any genetic model. In addition, the variant was not strongly associated with recurrence and death risk of ischemic stroke, as shown by the results. PMID: 28648959
- the expression of APLNR (APJ/AGTRL1), the only known receptor for apelin, is predominantly restricted to the endothelial cells. PMID: 28904225
- Studies suggest that apelin/APJ system may be applied to the treatment of cancers by regulating apoptosis, which may play a vital role in anticancer therapy [review]. PMID: 28407045
- Crystal structure of human APJR shows structural basis for apelin recognition and binding PMID: 28528775
- mutation of promoter polymorphism rs7119375 in APJ gene was significantly associated with elevated SBP and increased hypertension risk in Chinese women. PMID: 27863393
- The APLNR A445C polymorphism was not associated with diabetic retinopathy in a sample of the Tunisian population, but the CC genotype carrier patients with DR had a high total cholesterol concentration. PMID: 28182349
- APLN and APLNR are present in human ovarian cells and APLN increases IGF1-induced steroidogenesis in granulosa cells through an increase in HSD3B protein expression and activation of the MAPK3/1 and Akt pathways. Therefore, APLN and APLNR may play a role in human follicular development and the pathogenesis of PCOS. PMID: 27683264
- These results demonstrate a new pharmacologic property of protamine-blockade of APJ-that could explain some adverse effects observed in protamine-treated patients, and that the established antiangiogenic activity of protamine would rely on APJ antagonism. PMID: 28242772
- The apelin/APLNR axis regulates cholangiocarcinoma cell proliferation and tumor angiogenesis. PMID: 27894959
- Data suggest that the differential expression of Apelin and Apelin receptor APJ yields a "self-generated" gradient mechanisms that accelerates the extension of the sprout. PMID: 27828952
- The aim of this study was to evaluate if polymorphisms of APLN and APLNR genes may play a role as susceptibility markers for hypertension in a group of Mexican-Mestizo patients. PMID: 27450650
- review of the important role of the Apelin/APJ system in pathological angiogenesis PMID: 28025030
- The optimal gene-gene interaction model for both males and females with regard to hypertension was apelin rs3761581-apelin rs3115757-APJ rs7119375. In conclusion, gene polymorphisms of the apelin-APJ system are associated with susceptibility to hypertension. PMID: 27338090
- Up-regulation of apelin and APJ expression plays an important role in cardioprotection from myocardial ischemia/reperfusion injury. PMID: 27854125
- These findings suggested that Apelin/APLNR signaling may be used as a potential therapeutic target for hypoxic/ischemic injury. PMID: 26676468
- The expressions of apelin and APJ are significantly augmented by hypoxia through the hypoxia-inducible factor-1 alpha (HIF-1alpha) signaling pathway. PMID: 26436483
- obese (especially diabese) youngsters demonstrated lower serum apelin levels; the G212A polymorphism of the APLNR gene was found to exert a favourable effect on circulating apelin levels in childhood obesity PMID: 25060841
- Apelin-APJ system is a novel neurohormonal pathway, with studies to date suggesting that it may be of pathophysiologic relevance in Heart failure. PMID: 25795508
- apelin is produced by arterial endothelial cells (ECs) during embryogenesis, induces chemotaxis of venous ECs, and promotes the production of secreted Frizzled-related protein 1 by apelin receptor(+) ECs PMID: 25920569
- This minireview outlines key (patho)physiological actions of the AR, addresses what is known about signal transduction downstream of AR activation PMID: 25275559
- built 3 homology 3-D models of the ApelinR and revealed the conservation at the bottom of the apelin binding site of a hydrophobic cavity in which the C-terminal Phe of pE13F was embedded PMID: 25359495
- ERG and APLNR are essential for endothelial homeostasis in venules in the lung and that perturbation in ERG-APLNR signaling is crucial for the development of pulmonary veno-occlusive disease. PMID: 25062690
- AGTRL1 genetic polymorphisms might contribute to the development of hypertension independently and/or through complex interaction. PMID: 24465893
- serine 348 on the apelin receptor is a novel regulatory phosphorylation site in apelin-13-induced G protein-independent biased signaling PMID: 25271156
- APJ and B1R can form heterodimers in transfected HEK293 cells and activations of APJ and B1R could up-regulate eNOS phosphorylation PMID: 24686079
- REVIEW: Growing evidence shows that apelin/APJ system functions as a critical mediator of cardiovascular homeostasis and is involved in the pathophysiology of cardiovascular diseases. PMID: 24055369
- Apelin-APJ is overexpressed, and works as a signal for arteriogenesis in HCC. PMID: 25275024
- functional role of the apelin--APJ system likely in early gestation PMID: 23844873
- Apelin may be associated with proliferative vasculopathy in systemic sclerosis. PMID: 22112232
- Introduce a new correlative NMR spectroscopy and computational biochemistry methodology and demonstrate its utility in providing some of the first high-resolution structural information for a peptide-activated apelin receptor transmembrane domain. PMID: 23438363
- Interactive effects of genetic defects in apelin/APJ pathway might confer a potential risk in Chinese hypertensive patients. PMID: 23226564
- Apelin/APJ pathway serves as a critical intermediary that links statin to its pleiotropic effects in regulating endothelial gene targets and function. PMID: 22995518
- APELIN promotes hematopoiesis from human embryonic stem cells. PMID: 22611158
- the novel peptide apelin and its receptor APJ can induce the morphological and functional maturation of blood vessels in tumors PMID: 22037214
- There was an increased frequency of the G212 allele of AJP receptor in patients with hypertension in respect to patients without hypertension. PMID: 22109355
- hypoxia and inflammatory factors could play a major role in the activation of the hepatic apelin system leading to angiogenic and fibroproliferative response occurring in chronic liver disease. PMID: 21450694
- Disruption of apelin-APJ signaling can exacerbate pulmonary hypertension mediated by decreased activation of AMP-activated kinase and eNOS. PMID: 21233449
- Single nucleotide polymorphisms of the APLNR gene were significantly associated with diastolic blood pressure and mean arterial blood pressure responses to low-sodium intervention. PMID: 20125035
- found robust haplotype-based and haplotype-phenotype associations of four well characterized polymorphisms in apelin-AGTRL1 system with hypertension and related phenotypes PMID: 20485192
- These findings bring new insights into apelin receptor activation and show that Phe(255) and Trp(259), by interacting with the C-terminal Phe of the pyroglutamyl form of apelin 13 (pE13F) or K17F, are crucial for apelin receptor internalization. PMID: 20675385
- Our study indicates that genetic variation of APLN-APJ and ACE2 may influence BP response to potassium intake. PMID: 20224560
- The apelin/APJ system may be involved in retinal neovascularization during the development of proliferative diabetic retinopathy. PMID: 20220056
- These observations revealed a novel ligand-dependent targeting of the apelin receptor to beta-arrestin-associated and -dissociated trafficking pathways and a role for different Rab proteins to direct these pathways. PMID: 20353754
- Endothelial expression of apelin receptors is observed during the embryonic formation of blood vessels. The apelin system is both involved in physiological angiogenesis and pathological neoangiogenesis. Review. PMID: 19527631
顯示更多
收起更多
-
亞細胞定位:Cell membrane.
-
蛋白家族:G-protein coupled receptor 1 family
-
組織特異性:Expressed in heart, brain, kidney, stomach, spleen, thymus, lung, ovary, small intestine and colon, adipose tissues and pancreas. Expressed in glial cells, astrocytes and neuronal subpopulations. Expressed in embryonic (ESCs) and induced (iPSCs) pluripote
-
數據庫鏈接:
Most popular with customers
-
-
YWHAB Recombinant Monoclonal Antibody
Applications: ELISA, WB, IHC, IF, FC
Species Reactivity: Human, Mouse, Rat
-
Phospho-YAP1 (S127) Recombinant Monoclonal Antibody
Applications: ELISA, WB, IHC
Species Reactivity: Human
-
-
-
-
-